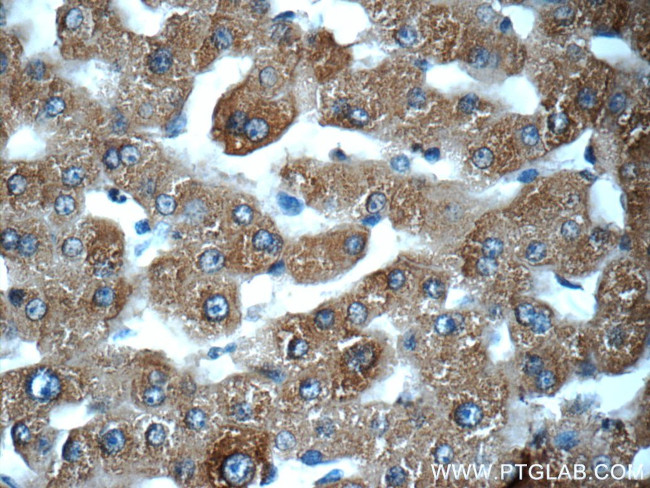
MBL2 Antibody in Immunohistochemistry (Paraffin) (IHC (P))

Search
Proteintech
MBL2 Polyclonal Antibody
{{$productOrderCtrl.translations['antibody.pdp.commerceCard.promotion.promotions']}}
{{$productOrderCtrl.translations['antibody.pdp.commerceCard.promotion.viewpromo']}}
{{$productOrderCtrl.translations['antibody.pdp.commerceCard.promotion.promocode']}}: {{promo.promoCode}} {{promo.promoTitle}} {{promo.promoDescription}}. {{$productOrderCtrl.translations['antibody.pdp.commerceCard.promotion.learnmore']}}
产品信息
24207-1-AP
种属反应
宿主/亚型
分类
类型
抗原
偶联物
形式
浓度
规格
纯化类型
保存液
内含物
保存条件
运输条件
产品详细信息
Immunogen sequence: ETVTCEDAQ KTCPAVIACS SPGINGFPGK DGRDGTKGEK GEPGQGLRGL QGPPGKLGPP GNPGPSGSPG PKGQKGDPGK SPDGDSSLAA SERKALQTEM ARIKKWLTFS LGKQVGNKFF LTNGEIMTFE KVKALCVKFQ ASVATPRNAA ENGAIQNLIK EEAFLGITDE KTEGQFVDLT GNRLTYTNWN EGEPNNAGSD EDCVLLLKNG QWNDVPCSTS HLAVCEFPI (21-248 aa encoded by BC069338)
靶标信息
MBL2 is a calcium-dependent lectin involved in innate immune defense. It binds mannose, fucose and N-acetylglucosamine on different microorganisms and activates the lectin complement pathway. It also binds to late apoptotic cells, as well as to apoptotic blebs and to necrotic cells, but not to early apoptotic cells, facilitating their uptake by macrophages. MBL2 may bind DNA.
仅用于科研。不用于诊断过程。未经明确授权不得转售。
生物信息学
蛋白别名: activates complement system; Collectin-1; Collectin1; mannan-binding lectin; Mannan-binding protein; Mannose-binding lectin; mannose-binding lectin (protein C) 2, soluble (opsonic defect); mannose-binding lectin 2, soluble (opsonic defect); Mannose-binding protein C; MBP-C; MBP1; MBPC; MGC116832; MGC116833
基因别名: COLEC1; HSMBPC; MBL; MBL2; MBL2D; MBP; MBP-C; MBP1; MBPD
UniProt ID: (Human) P11226
Entrez Gene ID: (Human) 4153